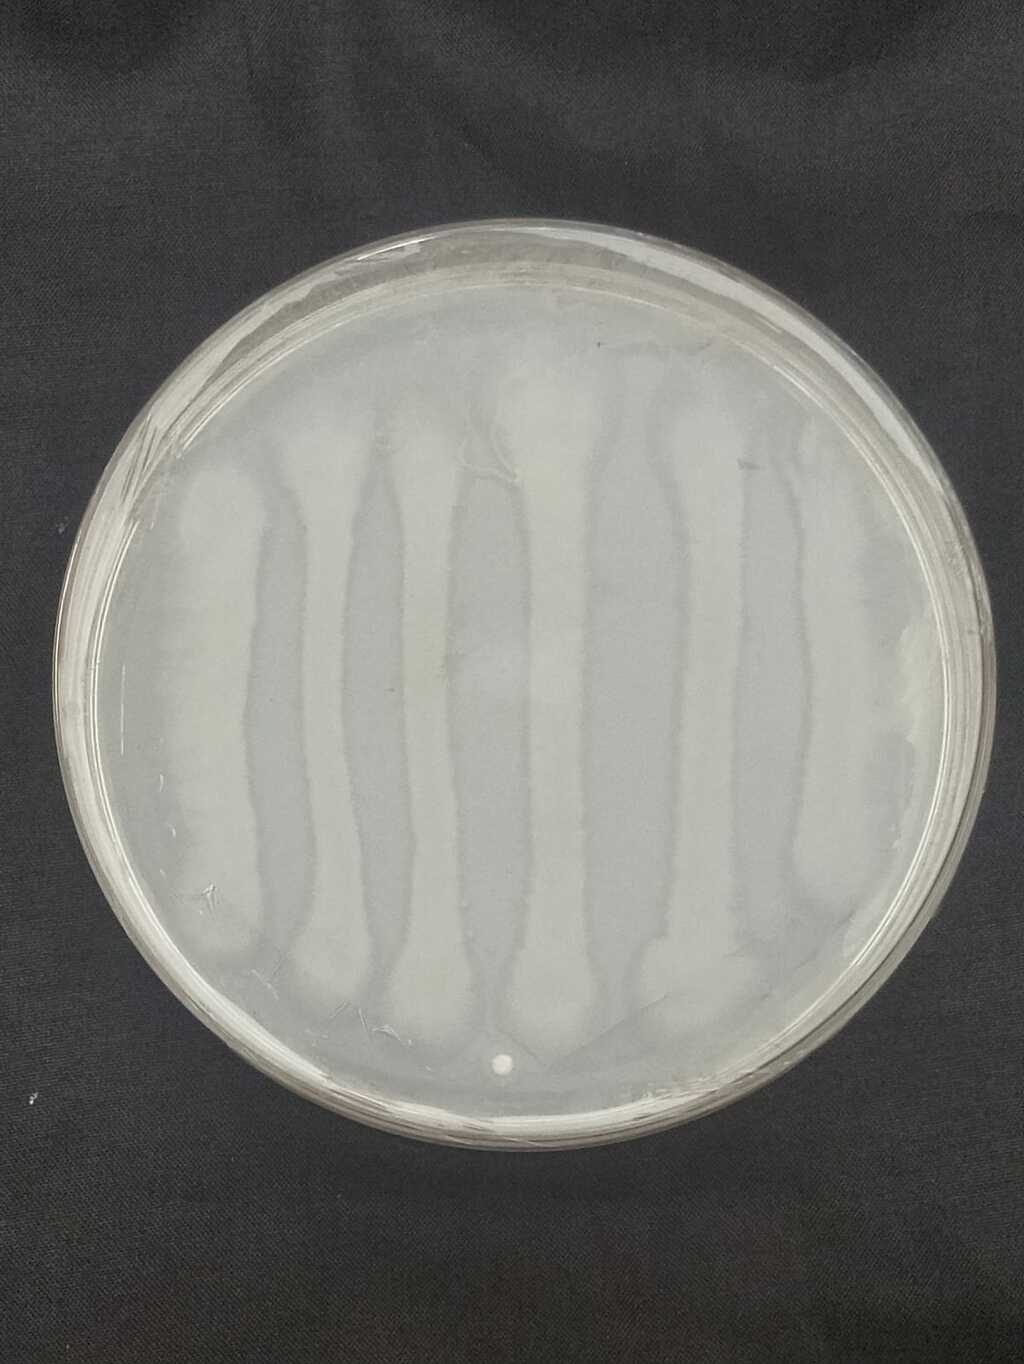
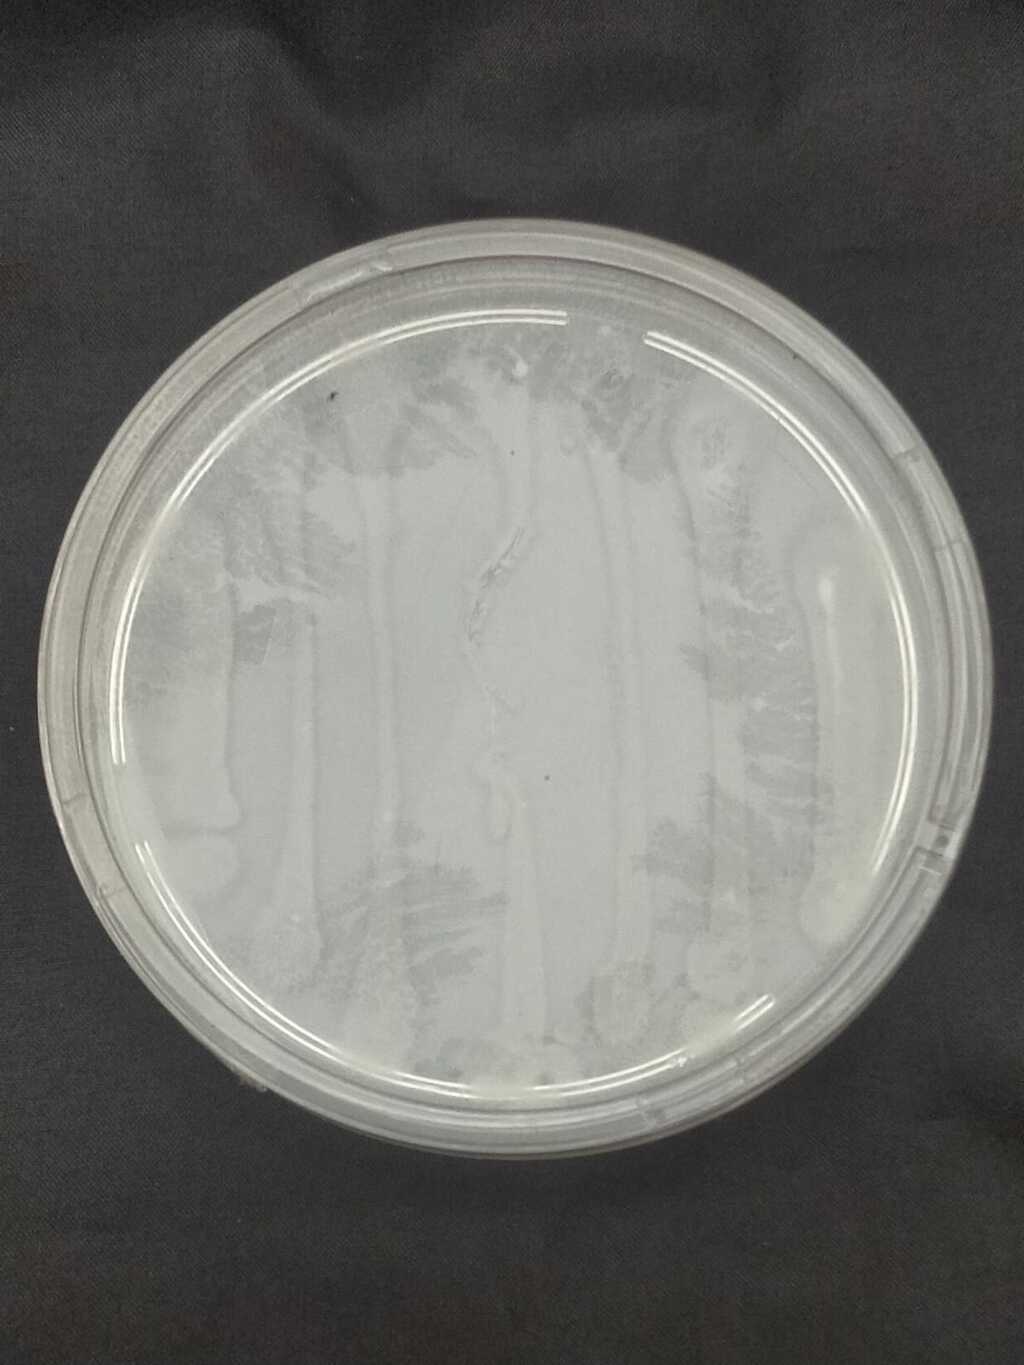
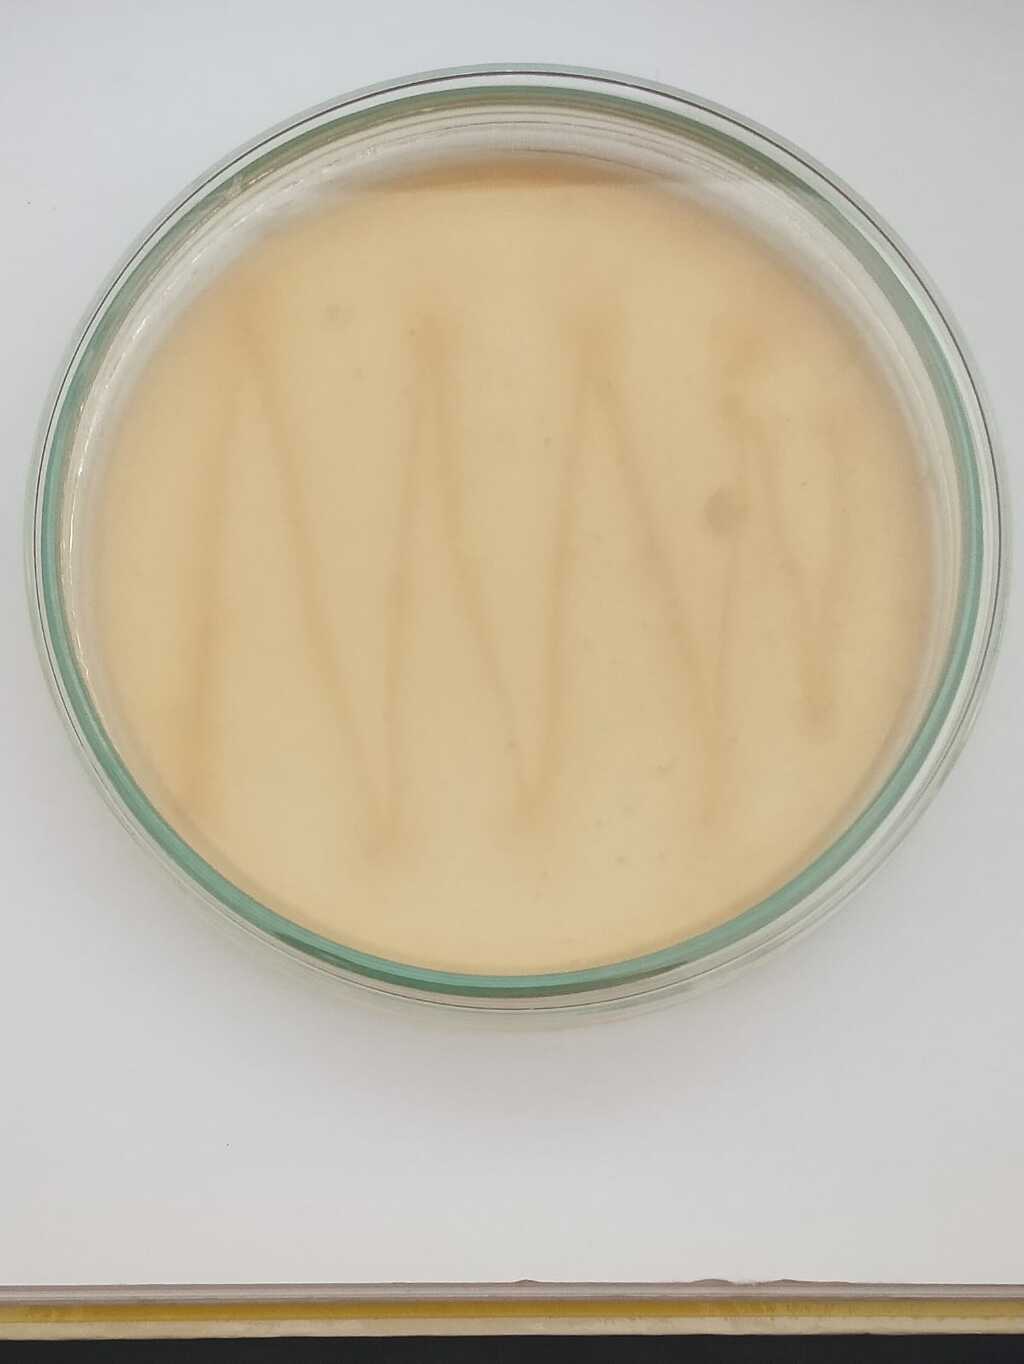
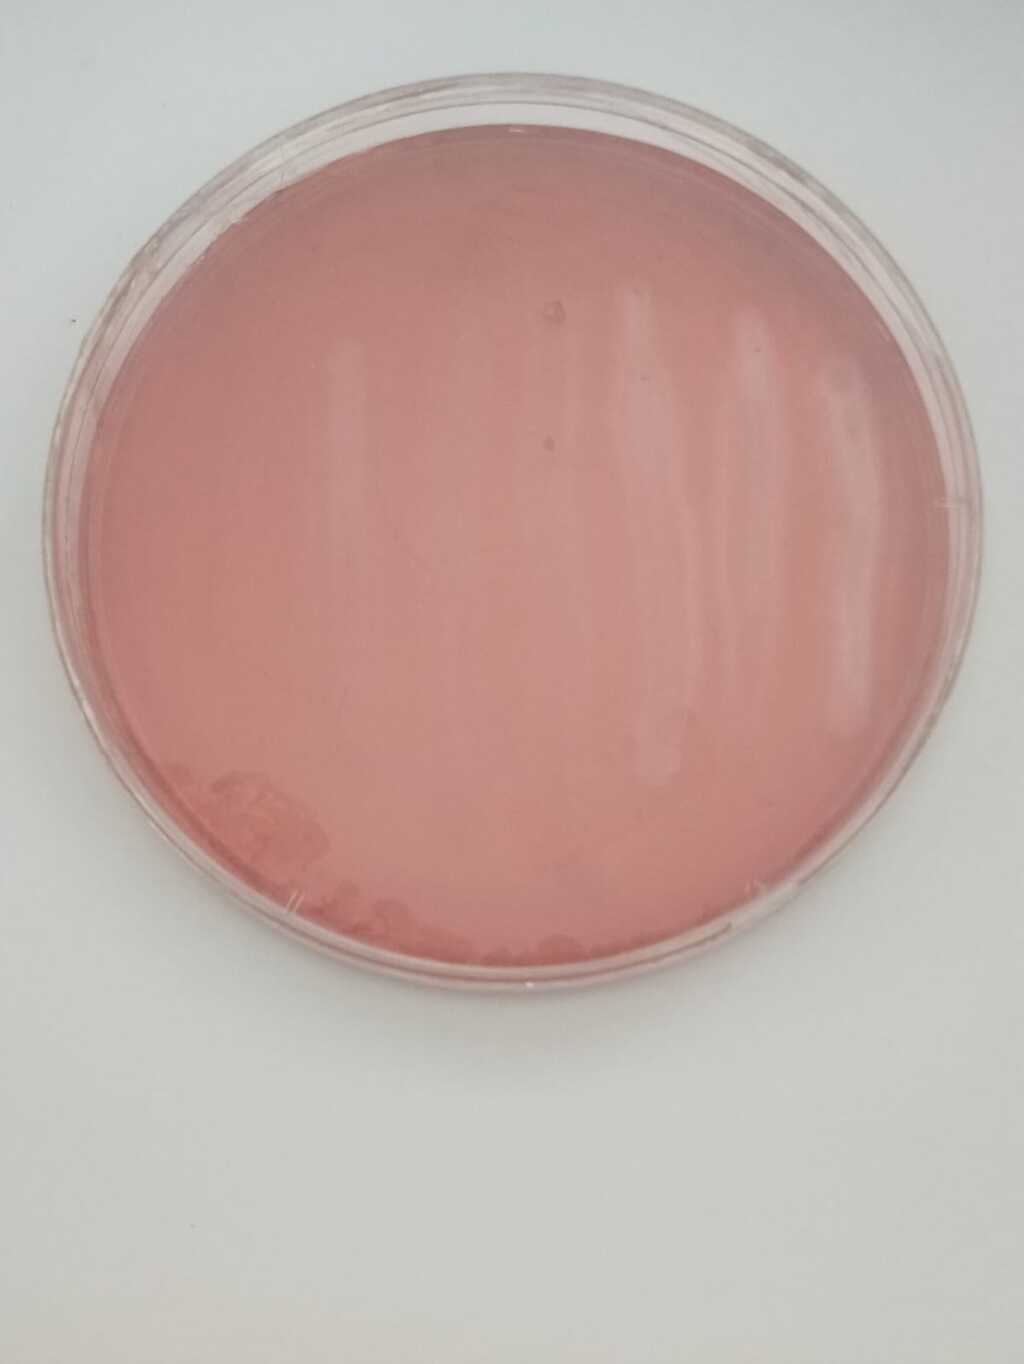
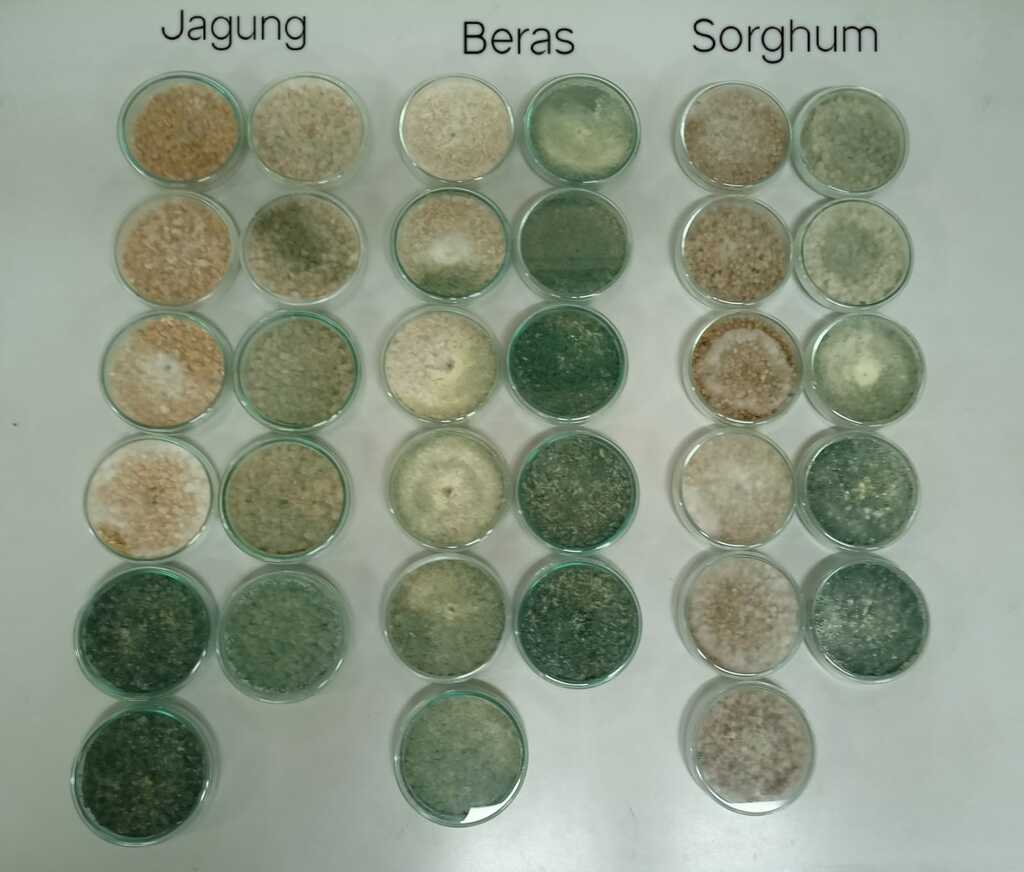
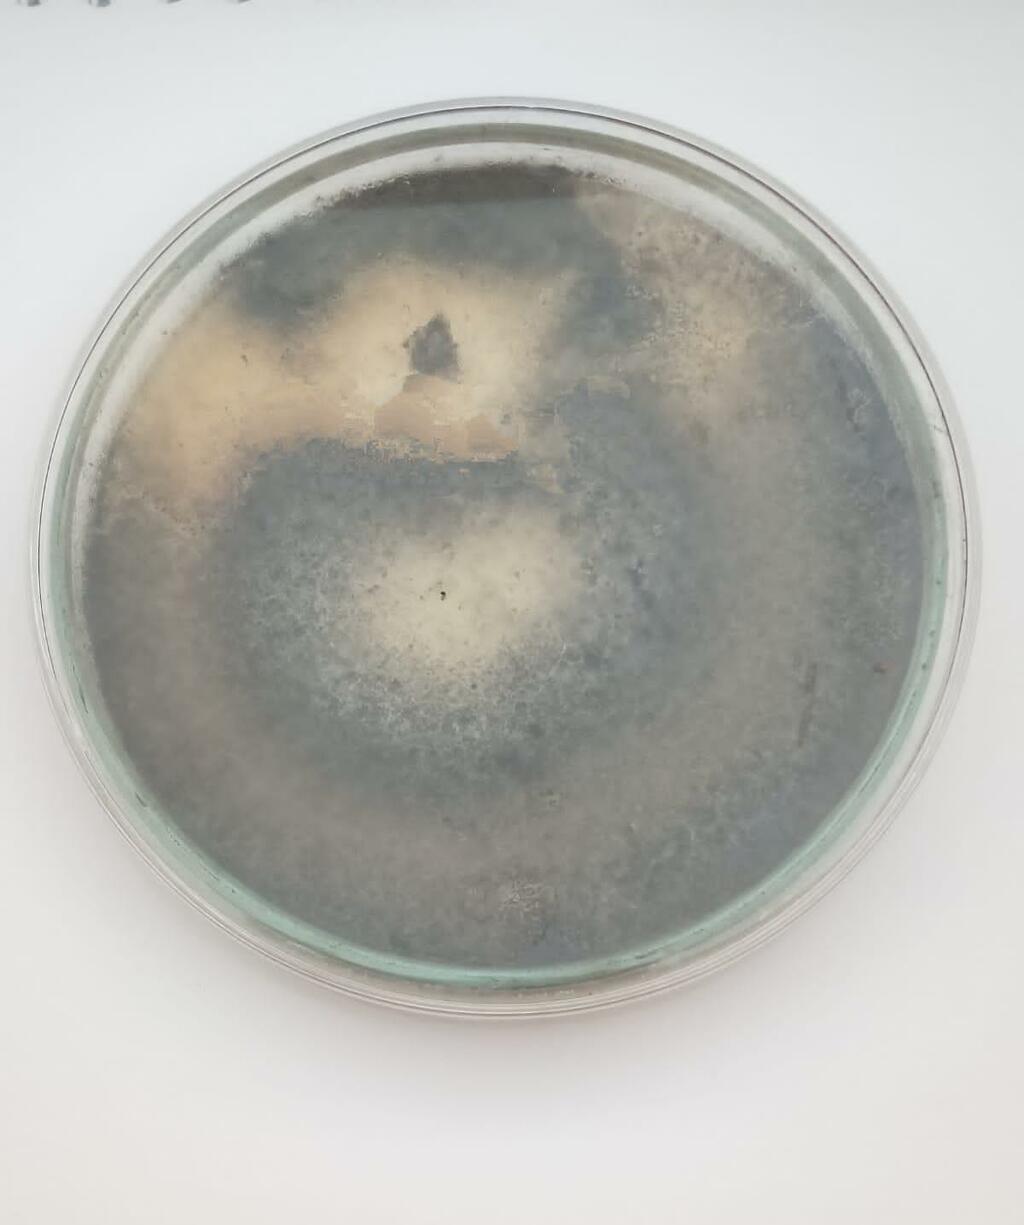

PT. Suryo Riset Indonesia (PT. SRI) adalah perusahaan riset dan inovasi di bidang pertanian, kehutanan, dan lingkungan berbasis teknologi mikrobial.
Perusahaan ini didirikan pada bulan Februari 2023 oleh Profesor Suryo Wiyono (Guru Besar Proteksi Tanaman sekaigus Dekan Fakultas Pertanian IPB University) dan Muhammad Nuramin. PT. SRI secara profesional berkomitmen melahirkan produk-produk inovatif berbasis teknologi mikrobial maupun professional assistance di bidang pertanian, kehutanan, pertambangan, dan lingkungan.
Melalui landasan keilmuan yang kuat dan jejaring kerjasama lintas disiplin, PT. SRI bertekad mendukung keberlanjutan sumber daya alam Indonesia dan meningkatkan kesejahteraan masyarakat melalui solusi bioteknologi berbasis mikroba.
Sebagai entitas yang mengusung profesionalisme dan integritas ilmiah, PT. SRI berkonsentrasi pada pengembangan dua pilar utama:
Tim PT. SRI merupakan tim profesional yang berkomitmen menghadirkan solusi inovatif dan berkualitas tinggi di bidang teknologi dan layanan. Dengan keahlian multidisiplin, tim kami dapat mengembangkan produk yang berorientasi pada kebutuhan pelanggan serta mendorong kemajuan industri melalui inovasi berkelanjutan dan kerja sama yang solid.
Kami mengolah berbagai kekayaan alam Indonesia menjadi produk inovasi bioteknologi berbasis mikroba yang memberi manfaat nyata bagi keberlanjutan umat manusia. Produk kami dirancang untuk menjawab tantangan di sektor pertanian, kehutanan, rehabilitasi lahan bekas pertambangan, dan pelestarian lingkungan.
Setiap produk kami dihasilkan melalui riset multi-disiplin dan pengujian lapangan intensif. Kami memastikan bahwa inovasi mikroba yang dikembangkan tidak hanya efektif, tetapi juga berkelanjutan. Memberi dampak positif jangka panjang bagi lingkungan dan kehidupan manusia.
Bersama kami, Anda tidak hanya menemukan ide segar, tetapi juga mitra yang siap mendukung setiap langkah inovasi dan kemajuan Anda. Mari bergandengan tangan, berbagi pengalaman, dan tumbuh bersama menuju masa depan yang lebih cerah dan berkelanjutan.
Layanan unggulan kami dirancang untuk memberikan solusi terpadu di bidang pertanian, kehutanan, pertambangan, dan lingkungan, dengan pendekatan berbasis microbial technology yang inovatif dan berkelanjutan.

Kami melakukan riset dan inovasi berbasis teknologi mikroba untuk menjawab tantangan di sektor pertanian, kehutanan, dan lingkungan (klinik dan perawatan taman). Fokus kami adalah menciptakan solusi berbasis sains yang aplikatif dan berdampak nyata di lapangan.

Tim ahli kami siap memberikan pendampingan profesional untuk membantu Anda merancang dan mengimplementasikan strategi yang tepat. Kami percaya bahwa kolaborasi yang kuat adalah kunci untuk mencapai tujuan bersama secara efektif dan berkelanjutan.

Kami memproduksi berbagai produk unggulan berbasis microbial technology yang mendukung aktivitas pertanian, kehutanan, pertambangan, dan pelestarian lingkungan. Setiap produk dikembangkan dengan standar kualitas tinggi untuk mendukung praktik yang ramah lingkungan dan efisien.
PT. SRI menjalin kemitraan strategis dengan berbagai institusi dan perusahaan yang memiliki komitmen terhadap riset, inovasi, dan keberlanjutan. Sebagai perusahaan yang fokus pada teknologi mikroba untuk sektor pertanian, kehutanan, dan lingkungan, kami percaya bahwa kolaborasi adalah kunci untuk menciptakan dampak nyata.
Bersama mitra kami, mulai dari lembaga penelitian, universitas, pelaku industri hingga komunitas lokal, PT. SRI mengembangkan solusi berbasis mikroba yang ramah lingkungan, efisien, dan aplikatif. Kemitraan ini mendukung pengembangan produk, perluasan penerapan teknologi, serta peningkatan kapasitas di lapangan.
Kami bangga dapat tumbuh bersama mitra-mitra hebat demi mendukung pertanian berkelanjutan, pelestarian hutan, dan perlindungan lingkungan.












Kami selalu terbuka untuk kolaborasi dengan mitra yang memiliki visi dan semangat yang sama dalam menciptakan inovasi dan solusi berkelanjutan. Bersama, kita bisa mewujudkan proyek yang berdampak positif dan memberikan manfaat nyata bagi banyak pihak. Jangan ragu untuk menghubungi kami dan mulai perjalanan kerja sama yang sukses.

Plant Promoting Rhizobacteria (PGPR) dengan strain C71 diterapkan dalam rangka pertanian sehat di desa penyangga Taman Nasional Gunung Ciremai

Pengukuran Caisin (Brassica chinensin var. parachinensin) di kebun sayur PT. Suryo Riset Indonesia untuk mengetahui pertumbuhan Caisin dari waktu ke waktu

Hasil panen jagung di kebun PT. Suryo Riset Indonesia yang hendak dipasarkan
Bakteri uji coba J8 Bacillus firmus

Bakteri uji coba C71 Lysibacillus fusiformis
Bakteri uji coba P3 Lactobacillus sp
Bakteri uji coba AP2 Pseudomonas aeruginosa
Bakteri uji coba Bervibaracterium linens D205

Monitoring pertumbuhan tanaman uji coba aplikasi PGPR C71 (kerja sama antara PT. SRI, Bogor Natur Indonesia (BNGi) dan Taman Nasional Gunung Ciremai

Perawatan Timun (Cucumis sativus) di kebun sayur PT. Suryo Riset Indonesia melalui penyiraman rutin setiap harinya

Potret sawah binaan PT. Suryo Riset Indonesia di Sambas-Kalimantan Barat yang siap panen
Hasil uji coba bakteri dan cendawan pada jagung, beras, dan sorghum



Kentang hasil uji coba PGPR C71
(Atas: Dengan perlakuan PGPR C71)
(Bawah: Tanpa perlakuan PGPR C71)

Perawatan Caisin (Brassica chinensis var. parachinensis) di kebun sayur PT. Suryo Riset Indonesia melalui penyiraman rutin setiap harinya

Hasil panen caisin di kebun PT. Suryo Riset Indonesia yang hendak dipasarkan

Cendawan uji coba Kutu Kebul

Cendawan uji coba Penicilium

Cendawan uji coba Lekania Endo Padi

Cendawan uji coba Nigrospora
Cendawan uji coba Trichoderma Harzarium

Cendawan uji coba Trichoderma Harzarium
13 Juni 2025
13 Juni 2025
13 Juni 2025
11 Juli 2025
8 Agustus 2025
1 September 2025
19 Februari 2026

PT. Suryo Riset Indonesia (PT. SRI) adalah perusahaan riset dan inovasi yang berfokus pada bidang pertanian, kehutanan, dan lingkungan...

Berkaca pada Ubud-Bali, lahan persawahan bisa disulap menjadi kawasan pariwisata berbasis pertanian (agrotourism)...

Dalam berbagai aspek kehidupan manusia, terdapat organisme mikroskopis yang memainkan peranan penting namun seringkali luput dari perhatian...

Kebijakan agraris yang memberikan keuntungan luar biasa kepada Pemerintah Kolonial Belanda namun juga...

Saat mendengar kata “padi”, mungkin yang terbayang adalah hamparan sawah luas yang tergenang air....

“Musim sudah tidak bisa ditebak lagi, terlebih cuaca Bogor” Kalimat itu sering kita dengar dari para petani...
13 Juni 2025
17 Juni 2025
2 Juli 2025
15 Juli 2025
15 Agustus 2025
4 Oktober 2025

Pada tahun 2024, PT. Suryo Riset Indonesia (PT. SRI) memulai langkah baru dalam mendukung konservasi dan kesejahteraan....

PT. Suryo Riset Indonesia (PT. SRI) memiliki beberapa jenis tanaman hortikultura...

Di Desa Pleret, Kecamatan Panjatan, Kabupaten Kulon Progo, Provinsi Daerah Istimewa Yogyakarta...

PT. Suryo Riset Indonesia (PT. SRI) dan IPB University telah cukup lama menjalin hubungan kerjasama...

Salinitas tinggi pada padi di wilayah pesisir pantai terjadi disebabkan oleh kadar garam yang terlampau tinggi...
